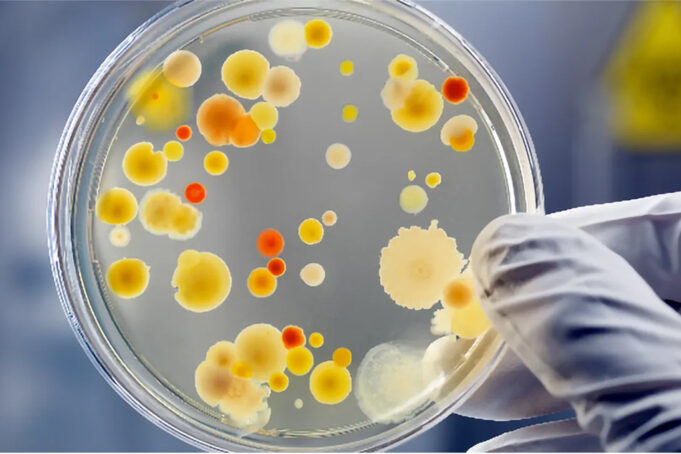
Ονοματολογία των μικροοργανισμών? Μα είναι τόσο εύκολο! πρωτοσέλιδο - Ονοματολογία των μικροοργανισμών? Μα είναι τόσο εύκολο!

Δείτε με ποιό τρόπο γίνεται η παρασκευή των τυριών με Όξυνση και Ενζυμική Διεργασία τύπου Quark - Να πώς εγώ φτιάχνω μαλακό αλειφόμενο τυρί τύπου Quark
Παρασκευή τυριών με: Όξυνση & Ενζυμική Διεργασία, τύπου Quark - Τί είδους τυριά είναι...
Φτιάχνω το προβιοτικό ρόφημα Şalgam στην κουζίνα μου – Σε αυτόν τον 4ο τρόπο οικιακής παρασκευής του Shalgam θα χρησιμοποιήσω και ζύμη (μαγιά) ψωμιού
Το Shalgam (ή Şalgam) είναι ένα παραδοσιακό προβιοτικό όξινο ποτό κόκκινου χρώματος, με προέλευση από την...
Δείτε ποιοί είναι οι 3 ή οι 4 τρόποι με τους οποίους παρασκευάζονται τα τυριά όλου του κόσμου
Οι 3 ή οι 4 τρόποι με τους οποίους παρασκευάζονται τα τυριά - Με ποιό τρόπο εγώ θα κάνω το γάλα να...
Ποιό ρόλο διαδραματίζουν οι ζυμομύκητες στα γαλακτοκομικά προϊόντα? Δείτε το πώς οι ζυμομύκητες προκαλούν κακή δομή και άσχημο flavor στα γαλακτοκομικά προϊόντα
Ζυμομύκητες και οξυγαλακτικά βακτήρια στα γαλακτοκομικά προϊόντα
Όταν αναφέρουμε την έννοια, μικροοργανισμοί εκκινητές, (starters) ή την έννοια, καλλιέργειες εκκίνησης ...
Ανεπιθύμητες οπές σε σκληρά τυριά - Τί είναι το φαινόμενο της όψιμης διόγκωσης στα σκληρά τυριά? Με ποιό τρόπο εγώ θα αντιμετωπίσω το ελάττωμα του όψιμου φουσκώματος στα τυριά?
Ανεπιθύμητες οπές σε σκληρά τυριά - Τί είναι το όψιμο φούσκωμα...
Ποιά Θερμόφιλα Οξυγαλακτικά Βακτήρια θα πρέπει εγώ να επιλέξω στην Γαλακτοκομία και στην Τυροκομία? Δείτε ποιό είναι το κατάλληλο Είδος καλλιέργειας για τον κάθε τύπο τυριού
Θερμόφιλα οξυγαλακτικά βακτήρια - Ποιά οξυγαλακτικά βακτήρια χρησιμοποιούνται στην Γαλακτοκομία και στην Τυροκομία?
Υπάρχουν 12...
Ποιοί είναι οι 3 τρόποι με τους οποίους εσείς μπορείτε να μετρήσετε την αλατοπεριεκτικότητα σε μια άλμη?
Να οι 3 τρόποι για να μετρήσετε την αλατοπεριεκτικότητα σε μια άλμη - Έχει σημασία εγώ να γνωρίζω την αλατοπεριεκτικότητα σε μια άλμη?
Η...
Ποιά Μεσόφιλα Οξυγαλακτικά Βακτήρια θα πρέπει εγώ να επιλέξω στην Γαλακτοκομία και στην Τυροκομία? Δείτε ποιό είναι το κατάλληλο Είδος καλλιέργειας εκκίνησης (starter cultures) για τον κάθε τύπο τυριού
Μεσόφιλα οξυγαλακτικά βακτήρια στην Γαλακτοκομία και στην Τυροκομία
Υπάρχουν 12 γένη των...
Ζυμομύκητες στα γαλακτοκομικά προϊόντα - Τί είναι οι ζυμομύκητες? Ποιός είναι ο ο ρόλος των ζυμομυκήτων στην παρασκευή των γαλακτοκομικών προϊόντων?
Με ποιό τρόπο επιδρούν οι ζυμομύκητες στα γαλακτοκομικά προϊόντα
Οι Ζυμομύκητες, ή οι ζύμες (yeasts) είναι μικροοργανισμοί, οι οποίοι είναι,...
Τί είναι τα ζυμωμένα γάλατα και τί είναι τα οξεογάλατα? Ποιό είδος ζύμωσης κυριαρχεί στα οξεογάλατα? Τί προϊόντα παράγονται κατά τις ζυμώσεις στα οξεογάλατα?
Ζυμωμένα γάλατα ή οξεογάλατα - Η ζύμωση των τροφών
Η ζύμωση, ως μια διαδικασία συντήρησης, των τροφίμων,...
Δείτε ποιοί είναι οι 2+1 τρόποι, τους οποίους, εμείς χρησιμοποιούμε ώστε να ξινίσουμε το γάλα
Η παρασκευή πολλών ειδών γαλακτοκομικών προϊόντων απαιτεί το ξίνισμα του γάλακτος.
Η όξυνση, του γάλακτος, προωθεί την αποσταθεροποίηση των καζεϊνικών μικκυλίων.
Αυτή η αποσταθεροποίηση μπορεί να...
Με ποιό τρόπο ο παράγοντας διατροφή θα επηρεάσει σημαντικά το Εντερικό Μικροβίωμα? Δείτε πώς το είδος της διατροφής θα καθορίσει την σύνθεση της Εντερικής Μικροχλωρίδας
Με τον όρο Εντερική Μικροχλωρίδα (gut microbiota), εμείς αναφερόμαστε στο σύνολο των μικροοργανισμών, οι οποίοι...
Ποιά είναι η συνήθης συνταγή όταν φτιάχνω το προβιοτικό ποτό Shalgam? Ας δούμε πρώτα το τί είναι το Şalgam
Το Shalgam (ή Şalgam) είναι ένα παραδοσιακό προβιοτικό όξινο ποτό κόκκινου χρώματος με προέλευση από την Τουρκία και συγκεκριμένα από την...
Τί είναι το γάλα μακράς διαρκείας (ΓΜΔ)? Πόση διάρκεια ζωής έχει το ΓΜΔ? Σε τί διαφέρει το γάλα μακράς διαρκείας με το γάλα υψηλής θερμικής επεξεργασίας (UHT)?
Τί είναι το γάλα μακράς διαρκείας? Ελάτε να δούμε ποιό είναι το ΓΜΔ
Πολλές...
Ποιοί μικροοργανισμοί είναι οι Πρωτογενείς Εκκινητές και ποιοί μικροοργανισμοί είναι οι Δευτερογενείς Εκκινητές στα γαλακτοκομικά προϊόντα?
Μικροοργανισμοί Πρωτογενείς εκκινητές και Μικροοργανισμοί Δευτερογενείς Εκκινητές στα γαλακτοκομικά προϊόντα - Οι ζυμώσεις στα γαλακτοκομικά προϊόντα
Η παρασκευή πολλών γαλακτοκομικών προϊόντων περιλαμβάνει την ζύμωση του...
Μπορούμε εμείς να ασχοληθούμε με την Οικιακή Παρασκευή των Ζυμωμένων Γαλάτων? Είναι εύκολο? Είναι δύσκολο? Μήπως είναι αναγκαίο?
Οικιακή Παρασκευή Ζυμωμένων Γαλάτων - Δεν υπάρχει διαφοροποίηση στα ζυμωμένα γάλατα τα οποία διατίθενται στην αγορά
Οι επιχειρήσεις μεταποίησης, του γάλακτος, και οι...
Τί είδους τυρί είναι το τυρί Μυζήθρα? Πώς εγώ μπορώ να φτιάξω, στο σπίτι, ένα delicatessen τυρί Μυζήθρα ?
Το τυρί Μυζήθρα - Ποιά είναι τα χαρακτηριστικά γνωρίσματα του τυριού Μυζήθρα
Το τυρί Μυζήθρα είναι ένα μαλακό τυρί τυρογάλακτος, έχει συμπαγή...
Οι ζυμομύκητες παράγουν διάφορα αρώματα και γεύσεις κατά την αλκοολική ζύμωση – Δείτε το τί είδους συστατικά δημιουργούνται στα ζυμωμένα τρόφιμα και ποτά
Γεύσεις και αρώματα από τους ζυμομύκητες κατά την αλκοολική ζύμωση – Ποιά είναι τα σημαντικότερα παραγόμενα συστατικά?
Οι...
Ποιές είναι οι ομοιότητες και ποιές είναι οι διαφορές μεταξύ του ζυμομύκητα Saccharomyces cerevisiae και του ζυμομύκητα Saccharomyces pastorianus – Τί θα πρέπει να ξέρω?
Ποιά είναι τα χαρακτηριστικά του ζυμομύκητα Saccharomyces cerevisiae και ποιά είναι τα χαρακτηριστικά του ζυμομύκητα...
Ποιά είναι η ζύμωση του μυρμηκικού οξέος? Ποιοί μικροοργανισμοί λαβαίνουν μέρος στην ζύμωση του μυρμηκικού οξέος? Ποιός είναι ο ρόλος, αυτής, της ζύμωσης στην παραγωγή των γαλακτοκομικών προϊόντων?
Η ζύμωση του μυρμηκικού οξέος ή η μικτή όξινη ζύμωση (mixed acid...
Ποιές είναι οι γαλακτοκομικές καλλιέργειες εκκινητές? Ποιοί είναι οι μικροοργανισμοί μη εκκινητές στα γαλακτοκομικά προϊόντα?
Γαλακτοκομικές καλλιέργειες εκκινητές στα γαλακτοκομικά προϊόντα – Ποιοί είναι οι μικροοργανισμοί της ''Μαγιάς''
Η παρασκευή, των περισσότερων γαλακτοκομικών προϊόντων (τυριών, γιαουρτιού, ζυμωμένων γαλάτων, κ.α.), απαιτεί την...
Με ποιό τρόπο εγώ θα φτιάξω τυρί χωρίς νάτριο? Τί θα πρέπει να ξέρω?
Τυρί χωρίς νάτριο - Το νάτριο αποτελεί ένα απαραίτητο συστατικό του ανθρώπινου οργανισμού
Το νάτριο (Na) είναι ένα απαραίτητο συστατικό για την δίαιτά μας.
Το νάτριο αποτελεί το...
Δείτε το πού οφείλεται το άρωμα διακετυλίου στα γαλακτοκομικά προϊόντα - Τί είναι η ζύμωση των κιτρικών ή η ζύμωση της 2,3-βουτανοδιόλης
Ποιοί μικροοργανισμοί είναι, κυρίως, υπεύθυνοι για το άρωμα διακετυλίου στα γαλακτοκομικά προϊόντα?
Τα οξυγαλακτικά βακτήρια (LAB) μεταβολίζουν την λακτόζη,...
Ποιά είναι η προπιονική ζύμωση ? Ποιά είναι η σημασία της ζύμωσης, του προπιονικού οξέος, στην παρασκευή των γαλακτοκομικών προϊόντων?
Τί είναι η Προπιονική ζύμωση? Ποιά Προπιονικά βακτήρια παρουσιάζουν ενδιαφέρον?
Η διεργασία της προπιονικής ζύμωσης συνδέεται, άρρηκτα, με την παρασκευή των...
Ποιές είναι οι προδιαγραφές στο παστεριωμένο γάλα? Ποιές είναι οι απαιτήσεις της Νομοθεσίας για την παστερίωση του γάλακτος?
Ποιές θα πρέπει να είναι οι προδιαγραφές στο παστεριωμένο γάλα? - Ποιός είναι ο ορισμός της παστερίωσης του γάλακτος?
Η έννοια της παστερίωσης,...
Πού χρησιμοποιούνται οι μεσόφιλες γαλακτοκομικές καλλιέργειες εκκινητών? Τί σημαίνει ο συμβολισμός O, L, D, LD, Cit+, Cit- στις μικροβιακές γαλακτοκομικές καλλιέργειες?
Γαλακτοκομικές μεσόφιλες καλλιέργειες εκκινητών - Σήμερα, την θέση της ''Μαγιάς'' έχουν πάρει οι καλλιέργειες τυροκομίας με την μορφή DVS
Απαραίτητη...
Ποιά σχέση έχει το παραγόμενο τυρί στην Ελλάδα με το εγχώριο γάλα? Πόσο ''λογική'' και πόσο παρωχημένη είναι η νομοθεσία?
Τυρί και Γάλα στην Ελλάδα - Μεταφορά γάλακτος all over Greece
Πολλές διαφημίσεις, μεγάλων μεταποιητικών μονάδων γάλακτος, έχουν ως θεματολογία, την...
Ποιοί είναι οι τρόποι για να αλατίσετε το τυρί - Δείτε τους 3+1 τρόπους για να αλατίσετε το τυρί σας
3+1 τρόποι για να αλατίσετε το τυρί - Ποιός είναι ο ρόλος του αλατιού (NaCl) στα γαλακτοκομικά προϊόντα?
Η σημασία, της...
Μπορεί η παστερίωση να κάνει ζημιά στο γάλα? Τί εγώ θα πρέπει οπωσδήποτε να γνωρίζω για την παστερίωση του γάλακτος?
Πόσο ζημιά κάνει η παστερίωση στο γάλα – Τί είναι η παστερίωση του γάλακτος
Η παστερίωση είναι η ηπιότερη θερμική επεξεργασία,...
Τί είναι οι μυκοτοξίνες και τί είναι οι αφλατοξίνες? Υπάρχουν μυκοτοξίνες και αφλατοξίνες στα γαλακτοκομικά προϊόντα?
Μυκοτοξίνες και Αφλατοξίνες στα γαλακτοκομικά προϊόντα - Τί είναι οι μυκοτοξίνες?
Οι μυκοτοξίνες είναι τα τοξικά προϊόντα μεταβολισμού ορισμένων μικροοργανισμών, οι οποίοι ανήκουν στις μούχλες...
Μπορώ εγώ να καταλάβω εάν πραγματικά παστεριώθηκε το γάλα μου? Τί θα πρέπει να προσέχω?
Με ποιό τρόπο εγώ θα καταλάβω το εάν παστεριώθηκε το γάλα μου ? Ποιά είναι η θερμική επεξεργασία του γάλακτος κατά την παστερίωση?
Η παστερίωση ορίζεται...
Δείτε ποιές είναι οι ευεργετικές επιδράσεις, των πρωτεϊνών, του γάλακτος - Ποιός είναι ο ρόλος, των πρωτεϊνών, του γάλακτος, απέναντι στον καρκίνο, στα μικρόβια, στους ιούς, στην τερηδόνα? Με ποιό τρόπο οι πρωτεΐνες, του γάλακτος, επιδρούν στον έλεγχο γλυκόζης,...
Ποιά είναι η βουτυρική ζύμωση? Ποιός είναι ο ρόλος της βουτυρικής ζύμωσης στην παραγωγή των γαλακτοκομικών προϊόντων?
Ποιά είναι η βουτυρική ζύμωση? Υπάρχει βουτυρικό οξύ στα γαλακτοκομικά προϊόντα?
Το βουτυρικό οξύ (CH3CH2CH2COOH) αποτελεί φυσικό συστατικό του γάλακτος.
Η περιεκτικότητα, του λίπους, του...
Εάν μπορούσα ποιό γάλα εγώ θα διάλεγα? Ποιά συστατικά περιέχει το γάλα από το κάθε είδος ζώου? Πόση πρωτεΐνη και πόσο λίπος περιέχει το γάλα?
Εάν μπορούσα ποιό γάλα θα διάλεγα? Το γάλα του Ανθρώπου
Το γάλα, του Ανθρώπου, είναι πολύ...
Πώς εγώ θα ''λευκάνω'' και πώς εγώ θα ''χρωματίσω'' το γάλα? Με ποιό τρόπο γίνεται η λεύκανση του γάλακτος? Με ποιό τρόπο γίνεται ο χρωματισμός του γάλακτος?
Πώς εγώ θα ''λευκάνω'' και πώς εγώ θα ''χρωματίσω'' το γάλα? Το αγελαδινό...
Ποιές είναι οι πρωτεΐνες του γάλακτος? Ποιές είναι οι καζεΐνες του γάλακτος? Ποιές είναι οι οροπρωτεΐνες του γάλακτος?
Πρωτεΐνες του γάλακτος - Καζεΐνες και Οροπρωτεΐνες
Το γάλα αποτελεί μια εξαιρετική πηγή πρωτεΐνης υψηλής ποιότητας.
Η περιεκτικότητα, του γάλακτος, σε πρωτεΐνη, θα εξαρτηθεί...
Δείτε γιατί το φως δημιουργεί δυσάρεστο flavor στο γάλα - Ποιά είναι η επίδραση της φωτοοξείδωσης στην ποιότητα του γάλακτος και των γαλακτοκομικών?
Γάλα + Φως = Δυσάρεστο flavor + Μείωση θρεπτικής αξίας - Με ποιό τρόπο επιδρά η φωτοοξείδωση...
Γιατί ξινίζει το φρέσκο γάλα όταν, εμείς αφήνουμε, αυτό, το γάλα, έξω από το ψυγείο? Ποιός είναι ο ρόλος των μικροοργανισμών στο ξίνισμα του φρέσκου παστεριωμένου γάλακτος?
Γιατί ξινίζει το φρέσκο γάλα όταν, εμείς αφήνουμε,αυτό, το γάλα, έξω από το...
Ποιά είναι η ζύμωση της 2,3-βουτανοδιόλης? Ποιά είναι η σημασία της ζύμωσης, αυτής, στην παραγωγή γαλακτοκομικών προϊόντων? Τί είδους αρωματικές ουσίες παράγονται κατά την ζύμωση των κιτρικών του γάλακτος?
Η ζύμωση της 2,3-βουτανοδιόλης είναι το ίδιο πράγμα με την ζύμωση...
Τί δηλώνουν τα ονόματα στους μικροοργανισμούς? Κατανοήστε την ονοματολογία των μικροοργανισμών με απλό τρόπο!
Ονοματολογία των μικροοργανισμών - Η ποικιλομορφία των γαλακτοκομικών προϊόντων οφείλετα στην δράση των μικροοργανισμών
Η διαδικασία της παραγωγής, της πολύ μεγάλης πλειοψηφίας, των γαλακτοκομικών προϊόντων, εμπλέκει την...